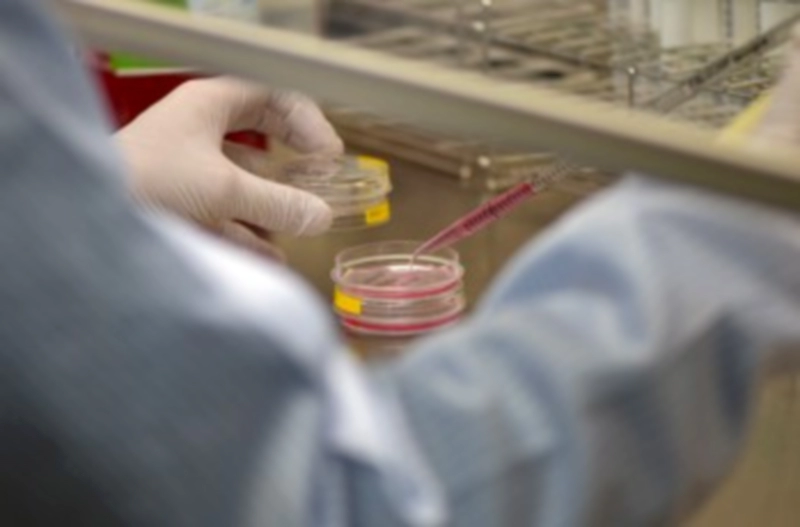
에스바이오메딕스 기업정보

세포치료제 개발기업 에스바이오메딕스가 기술특례상장을 통해 4월에 코스닥 시장에 입성 준비를 하고 있습니다. 이는 지난 2020년 상장을 추진하다 철회한 이후 3년 만입니다.
이러한 와중에 에스바이오메딕스이 연세대 의대 세브란스병원에서 파킨슨병 세포치료제 후보물질인 ‘A9-DPC’의 연구윤리심의위원회(IRB)로부터 최종 승인 받아 임상시험을 진행할 예정인 호재가 나와 더욱 상장에 관심도가 높아지고 있습니다.
이에 에스바이오메딕스 코스닥 상장을 위한 수요예측과 공모일정 그리고 기업정보에 대해 정리해보았습니다.






에스바이오메딕스 수요예측 및 공모주 상장
에스바이오메딕스 강세일 대표는 3월 28일 수요예측을 앞두고 공모 자금을 질환특이적 세포치료제 임상 개발에 투자해 치료제가 없는 난치성 질환 분야에서 블록버스터 세포치료제를 개발하겠다고 말했습니다.
에스바이오메딕스는 하나의 세포가 여러 질병을 타깃하는 기존 세포치료제 한계를 극복하기 위해 특정 질병에 특정 세포를 사용하는 질환특이적 세포 치료제를 개발하는 기업으로 이번 상장 도전은 2020년 상장 자진철회한 후 3년여 만에 재도전입니다.


에스바이오메딕스의 총 공모주식수는 75만 주, 공모예정가는 1만6000원~1만8000원입니다. 밴드 상단 기준 총 공모금액은 135억원이며 예상 시가총액은 1979억 원입니다.
상장예정 주식수는 1092만 2276주로 애초 3월 8일부터 기관투자자를 대상으로 한 수요예측을 진행할 예정이었으나 3월 28일 ~ 29일로 변경되었습니다.

청약 예정일은 내달 3~4일이며 투자업계에 일각에서는 회사의 공모예정가가 하단인 1만 6000원이 될 것이라는 전망이 나오고 있습니다.



에스바이오메딕스 기업정보 및 PDF 다운로드
에스바이오메딕스는 2003년 설립된 세포치료제 특화 재생의료 전문기업으로 줄기세포 치료제의 개발 및 제조를 전문으로 하고 있습니다.
회사는 국제 표준화 배아줄기세포 분화기술(TED)과 3차원 세포 스페로이드 구현 기술(FECS) 등 2개의 원천 플랫폼 기술을 기반으로 세부 기술을 보유하고 있습니다.






현재 8개의 파이프라인을 보유하고 있으며 그 중 파킨슨병 치료제(TED-A9), 척수손상치료제(TED-N), 중증하지허혈치료제(FECS-Ad), 눈가주름 개선(FECS-DF) 등 5개는 임상 단계에 있습니다. 또한, 국내를 비롯해 미국, 유럽, 일본 등에 132건의 특허를 출원해 그 중 87건의 등록을 완료한 상황입니다.

지난해 3분기 기준 에스바이오메딕스의 매출액은 2억 9937만원이며 영업손실은 2020년 84억원, 2021년 46억원, 2022년 3분기까지 22억원으로 감소세이며 지난해 120억 매출을 달성하였습니다.
상장을 준비중인 강세일 대표는 “이번 공모를 통해 모집한 자금은 임상에 투자할 계획이며 이로써 질환특이적 세포치료제 시장을 선도할 수 있도록 임상 연구에 박차를 가해 ‘블록버스터 세포치료제’라는 성과로 보답하겠다고 밝히고 있습니다.








